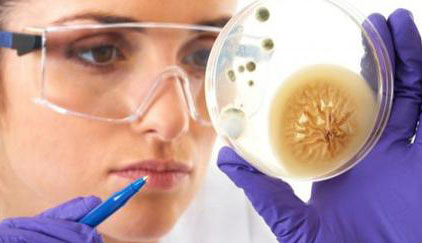
Инфекционное отделение

Отделения
В составе крупнейшей детской клинической больницы — более двадцати профильных стационарных отделений на 815 коек. Ежегодно в клинике получают квалифицированную медицинскую помощь свыше 100 тысяч детей, в том числе и в рамках федеральной программы «Здоровье» по оказанию высокотехнологичной медицинской помощи (ВМП) в счет средств федерального бюджета РФ.
Обращаем ваше внимание! Плановая госпитализация детей в клинику ФГБОУ ВО СПбГПМУ Минздрава России возможна
на бесплатной основе (за счёт средств федерального бюджета или средств ОМС)
на платной основе
или за счет средств ДМС.

Педиатрические отделения
Специализированные отделения
Хирургические отделения

Анестезиология-реанимация
Приоритетными направлениями совместной работы отделения и кафедры являются регионарная анестезия, новые методы ведения пациентов в палате реанимации (Fust-track), УЗИ - навигация при проведении регионарных блокад, в том числе продленных и при катетеризации магистральных сосудов.

Вспомогательные отделения
Отделение анестезиологии и реанимации, отделение диализа (искусственной почки), отделение переливания крови

Микрохирургическое отделение
Болезни сосудов, онкологические заболевания, костно-пластическая хирургия, реконструктивно-восстановительная хирургия кисти, хирургия пищевода, комплексное лечение синдрома портальной гипертензии, челюстно-лицевая и косметическая хирургия, специализированная нейрохирургическая помощь, микрохирургия в рамках других специальностей
Диагностика

Лаборатории
Бактериологическая лаборатория, Вирусологическая лаборатория, Клинико-биохимическая лаборатория

Лучевая диагностика
Компьютерная (КТ) и магнитно-резонансная (МРТ) томография. Ультразвуковые исследования (УЗИ). Исследования ЦНС, внутренних органов, глаз, суставов, сосудов у детей любого возраста по любым показаниям